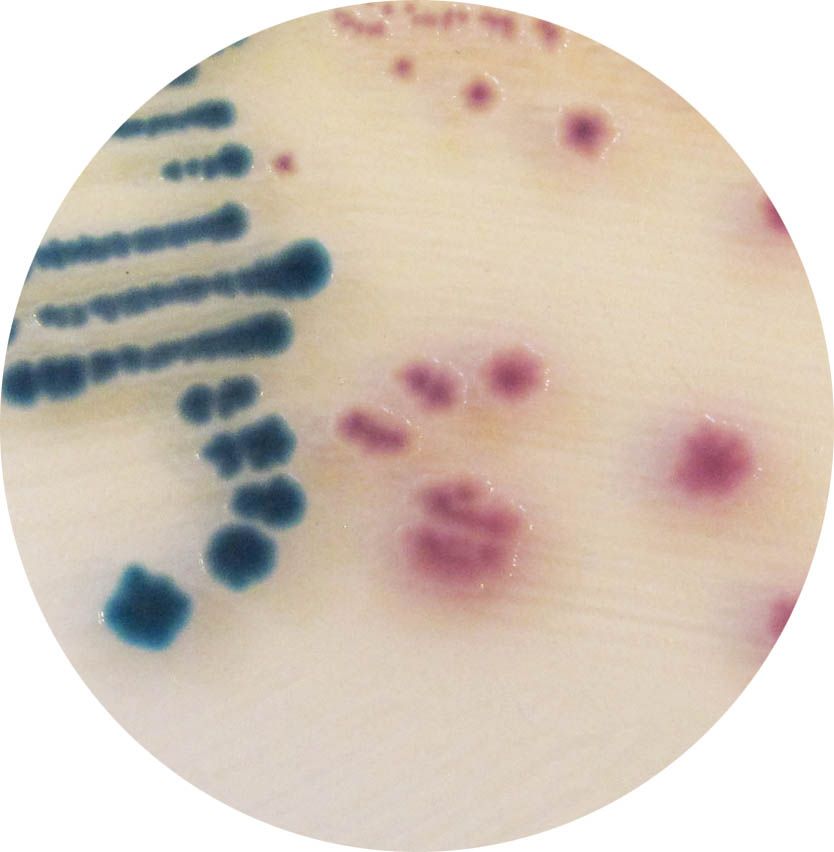
CHROMagar™ Y.enterocolitica - 5000 ml

SU703-25
Supplement to be added to the selected CHROMagar™ media in order to obtain an opaque background
Package size: 25 L
DKK 75,00
DKK 3.000,00
In stock, delivery 1-2 days
Chromogenic medium for detecton and diferentaton of pathogenic Yersinia enterocolitca.
The product is composed of a powder base (B) and 1 supplement (S).
TYPICAL APPEARANCE OF MICROORGANISMS:
Pathogenic Y.enterocolitica → mauve
Non pathogenic Y.enterocolitica and Background flora (Citrobacter, Enterobacter, Aeromonas etc) → Metallic blue, inhibited or limited growth in metallic blue colour
MEDIUM PERFORMANCE:
HIGH SPECIFICITY OF THE MAUVE COLOUR
1. Clear differentiation of Yersinia among background flora. Background flora, such as Citrobacter, often has a Yersinia-like red aspect on CIN agar which generate a heavy routine workload on false positive results. Thanks to CHROMagar™ Y.enterocolitica, this unnecessary workload will be eliminated as only pathogenic Yersinia enterocolitica colonies will grow mauve.
2. Colourful differentiation of pathogenic among non pathogenic Yersinia enterocolitica. In traditional culture media like CIN agar, pathogenic and non-pathogenic biotypes have the same aspect. On CHROMagar™ Y.enterocolitica, the pathogenic biotypes grow in a distinctive mauve colour, differentiated at a glance, from the non pathogenic which will grow metallic blue.
HIGH SELECTIVITY: REDUCTION OF BACKGROUND FLORA
Background flora is dramatically reduced on CHROMagar™ Y.enterocolitica allowing an easy reading of the plates. The laboratory will concentrate its efforts and resources only on suspect colonies that have a real potential of pathogenicity.
Among the Yersinia genus, Yersinia enterocolitca is one of the most common food borne pathogen. In several countries, Y. enterocolitca has eclipsed Shigella and approaches Salmonella and Campylobacter as the predominant cause of acute bacterial gastroenterits. Its ability to grow at refrigeraton temperature makes it an increasing concern in terms of food safety.
This germ most commonly afects young individuals. However, only a few strains of Y. enterocolitca cause illness in humans.Those pathogenic Y. enterocolitica strains belong to biotypes 1B, 2, 3, 4, and 5, whereas biotype 1A strains are non-pathogenic and widespread in the environment. The major animal Y. enterocolitica reservoir causing illnesses are pigs.